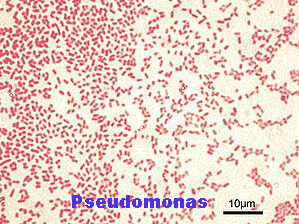

Nga Dr Atalvin Zhiva:
-Infeksionet e veshit(Otitis Externa)-
Siç paraqitet dhe në figurë veshi i qenit(kanali) është i përbërë nga komponentë vertikalë dhe horizontal.Kjo strukturë predisponon qentë për infeksione të shpeshta të veshit, mbeturinat që dalin nga veshi kanë rrugë më të gjatë për të bërë që të dalin në një vënd të drejtë për të dalë nga veshi.
Sëmundjet e veshit zakonisht e kanë burimin e tyre nga prodhimi i dyllit, e cila prodhohet si kundërpërgjigje e nje acarimi/irritimi të veshit.
Sëmundjet alergjike të lëkurës , veçanërisht kur kemi raste ripërsëritjeje, janë një shkak i mundshëm i ketyre irritimeve të veshit.
Shkaqe të tjera mund të jenë parazitat e veshit (ear mite), trupat e huaja të tilla si barëra të ndryshëm, ose dhe rritja e qimeve në brëndësi të kanalit të veshit ,gjë e cila ndodh shpesh në rracat leshtore dhe me veshë të varur ( Poodle, Schnauzers etj).
Lageshtia e krijuar nga dylli promovon rritjen e baktereve dhe infkesioneve.Shpejt dylli në vesh bashkohet me qelb.
Nuk merr shumë kohë që kafsha të shfaqi shenjat e para duke kruar veshin, duke tundur kokën dhe duke e mbajtur njërin vësh të varur posht.Rrjedhjet dhe aromat që vijojnë nga veshi mund të dallohen nga pronari.
Komplikimet me paraliza të fytyrës.
Nëse infeksioni arrin veshin e mesëm, kafshët e prekura mund të ketë një anim kokë, mungesë të balancës, dhe e pazakontë është lëvizja e syrit majtas-djathtas e quajtur “nistagmus”. Këto simptoma quhen shënja vestibulare dhe përfaqësojnë një komplikacion të infeksionit të veshit të mesëm. Infeksionet e veshit të mesëm mund të shkaktojnë edhe paraliza të nervit të fytyrës, duke çuar në një pamje të plogët dhe muskuj pa funksion në atë anë të fytyrës.
Hematomat e Aurolës(auricular) së veshit.
Kur një qen/macja fillon dhe kruan veshin, duke përdorur thonjtë ose duke tundur kokën fuqishëm ,mund te këputen disa nga enët e gjakut që ndodhen me shumicë në llapën e veshit .Kjo çon në gjakderdhje ashtu siç tregohet në foto.Rekomandimi në këtë rast është që duhet hequr gjaku i mpiksur dhe te pastrohet mire veshi kur qeni është në anestezi.
Trajtimi i infeksionit te veshit.
Hapi i parë:
Shumica e veshëve të infektuar pastrohen duke përdorur pastrues te posaçëm të ndjekur nga mjekimet përkatëse.Nëse ka vetëm mbeturina të buta dhe te vogla zakonisht nje dezifiektim dhe pastrim i vetëm është e mjaftueshme, por në disa raste është e nevojshme një pastrim i plotë i kanalit të veshit për të bërë një egzaminim të saktë të kanalit.Për komoditetin e pacientit ne rekomandojmë përdorim të qetësuesve në këtë proçedurë pasi veshi është i dëmtuar dhe i ndjeshem ndaj manipulimeve.
Një mostër e marrë nga mbetjet qe janë në kanalin e veshit merret dhe me të bëhet një lamë miksroskopike për të ndihmuar në vendosjen se cilat barna janë të nevojshme të dergohen në shtepi me qenin.Pas disa javësh te trajtimit ne shtepi , Mjeku Veteriner bën një rikontroll të kanalit të veshit për tu siguruar që infeksioni është zhdukur.Në shumicën e rasteve ky trajtim është i mjaftueshëm por kemi dhe raste “kokëfortë” për të cilët duhet të kalojmë në një tjeter hap.
Hapi i dytë:
Disa qen kanë probleme kronike të veshit në të cilat infeksioni ose nuk është kontrolluar nga mjekmi i përgjithshëm, ose rifillon sapo ndërpriten mjekimet që janë dhënë.Në këto rastë na duhet të bëjmë një kulturë të rrjedhjeve apo mbetjeve që gjenden në kanalin e veshit, në këtë mënyrë kemi një saktësi në gjendjen e organizmave dhe bëhet një trajtim specifik i infeksionit.Trajtimi duhet vazhduar rregullisht dhe në shtëpi me larjen e vesheve me solucionin përkatës sa herë të përshkruhet nga veterineri.
Analiza të mëtejshme mund të kërkohen në mënyrë që të përcaktohet arsyen pse infeksioni përsëritet.Alergjia është zakonisht arsyeja më e shpeshtë per problemet e përsëritur të veshit, gjithashtu një nga shkaqet mund të jetë dhe pabarazia e hormoneve.
Hapi i tretë:
Disa infeksione të veshit thjesht nuk mund të kontrollohen me hapat e sipërpërmendur.Keto raste kanë kapërcyer mundësine e trajtimit dhe kërkojne ndërhyrje kirurgjikale.
Vërehet një përhapje e bakterieve në kanalin e veshit.Sharkimet bakteriale mund të fshihen ku të mundin.Kanali vertikal hapet për të pasur mundësi pastrimi më të plotë të tij.
Varet nga shkalla e problemit , mund të shihet e nevojshme ndërhyrja kirurgjikale për të hapur kanalin vertikal.Kjo mundëson që të hiqën mbeturinat që janë aty në mënyrë më efikase.
Nëse kanali është infektuar aq keq sa nuk mund të bëhet hapja e tij atëhere heqja e plotë e tij mund te jetë opsioni i vetëm.Në këtë procedurë kirurgjikale hiqet kanali plotësisht, në këtë mënyrë ju japim mundësi indeve të shëndetshme të rriten përsëri.Megjithëse operacioni mund të jetë i kushtushëm kemi raste të qenve me semundje kronike të rënda të veshit ( otitis externa)të cilët nuk kanë pasur nevojë për trajtime të mëtejshme për gjithë jetën.
Disa informacione rreth infeksioneve Pseudomonas
Kur bejme metoden e Gram staining, shohim se bakteriet Gram Negative janë me ngjyre roze.Ne fakt bakteriet Gram negative jane me rezistente ndaj antibiotikeve se bakteriet Gram positive( te cilat marrin një ngjyrosje në blu në metoden me ngjyrosje).Pseudomonas është veçanërisht rezistent dhe i aftë për t’u bërë akoma më shumë rezistente nëse trajtimi nuk është vendimtar dhe i fuqishëm që nga fillimi. Është mirë që infeksionit të veshit ti bëhet kultura në mënyrë që të gjejmë që në fillim nëse infkesioni është Gram negative apo që të identifikojnë Pseudomonas dhe të marrin masa të përshtatshme sa më shpejt të jetë e mundur.Pra të fillojmë antibiotikun e duhur në kohën e duhur.
Aeruginosa Pseudomonas është një specie e veçantë e bakterieve që është rezistente ndaj pothuajse gjithe llojeve të antibiotikëve. Është e zakonshme për infeksionet e veshit që të përsëriten dhe me kalimin e kohës, janë përdorur shumë antibiotikët. Është për të ardhur keq pasi shumica e bakterieve janë vrarë por duke lënë infeksionin më shumë rezistent dhe praktikisht të pavdekshme në brëndësi të veshit – Pseudomonas – .Për të mos përmendur që shkakton erën e keqe dhe qelbin në kanalin e veshit.
Aeruginosa Pseudomonas është një specie e veçantë e bakterieve që është rezistente ndaj pothuajse gjithe llojeve të antibiotikëve. Është e zakonshme për infeksionet e veshit që të përsëriten dhe me kalimin e kohës, janë përdorur shumë antibiotikët. Është për të ardhur keq pasi shumica e bakterieve janë vrarë por duke lënë infeksionin më shumë rezistent dhe praktikisht të pavdekshme në brëndësi të veshit – Pseudomonas – .Për të mos përmendur që shkakton erën e keqe dhe qelbin në kanalin e veshit.
Në disa raste me fat kultura e bërë do të tregojë që Pseudomonas vazhdon te jetë sensitive ndaj disa antibiotikeve orale si psh enrofloxacina dhe orbifloxacina.Duhet theksuar se dozat e këtyre antibitokëve jepen të larta në maksimumin e mundshëm për të bërë të mundur luftimin fuqishem të Pseudomonas pasi dozat jo te plota do ta bëjnë infeksionin më shumë rezistent dhe trajtimi bëhet akoma më i vështirë.
Trajtimi oral është i kombinuar në përgjithësi me një trajtim topikal.Fatmirësisht janë disa përzirje të cilat japin efekt të pëlqyeshëm dhe veterinëret mund ti përgatisin në klinikat e tyre.
Silvadene/silver sulfadiazine
Ky produkt gjendet në formën e një kremi që trajton plagët e ndryshme dhe është jashtzakonisht frytdhënës në përdorimin dhe trajtimin të pjesëvë të jashtmë të irritimit tek veshi.Gjithashtu ka aktivitet luftues ndaj disa bakterieve përfshirë Pseudomonas.Kremi mund te hollohet me pak ujë për një përdorim më të lehtë tek infeksioni i veshit.Ky është një produkt me efekt shumë të mirë edhe në rastet kur Pseudomonas është rezistent ndaj antibiotikëve të përdorur në rruge topikale.
Tris-EDTA
EDTA është një kordon i metaleve që janë të rëndësishëm për muret e qelizave.Tris është përdorur për ta përshtatur EDTA në një Ph që nuk është irrituese për veshin dhe për të maksimizuar efektin anti-bakterial.Duke përdorur Tris_EDTA i japim me shumë fuqi antibiotikëve të përdorur njekohesisht për të luftuar infeksionin e veshit.
Trajtimet me injeksione
Është e pazakontë për një specie të Pseudomonas të jetë rezistente ndaj absolutisht çdo gjë. Nëse për disa arsye pronarët nuk mund të bëjnë një trajtim oral qenit të sëmurë,atëhere ata mund të provojnë të japin trajtime me anën e injeksioneve. Edhe këto trajtime(ato me anën e injeksionit) mund të kombinohen me trajtimet topikale.
Deshëm të rikujtomë se trajtimet e infeksioneve të veshit kërkojnë një bashkëpunim dhe mirëkuptim të plotë midis pronarit dhe veterinerit.
Dr Atalvin Zhiva
Materiali është pronë e revistës onlinë “Mjekësia Veterinare Shqiptare” ,
nuk lejohet publikimi , apo përdorimi i këtij materiali , pa lejën e redaksisë .


